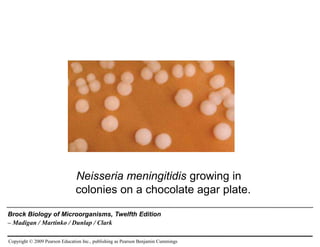
Click to add Text
Copyright © 2009 Pearson Education Inc., publishing as Pearson Benjamin Cummings
Brock Biology of Microorganisms, Twelfth Edition
– Madigan / Martinko / Dunlap / Clark
Neisseria meningitidis growing in
colonies on a chocolate agar plate.

The document explores the phylum Proteobacteria, a significant group of diverse and metabolically versatile bacteria characterized by varied shapes and gram-negative cell walls. It details various classes within Proteobacteria, including alpha, beta, gamma, delta, and epsilon, along with specific genera, their ecological roles, and pathogenic potential. Additionally, it discusses the phototrophic, chemolithotrophic, and methanotrophic adaptations of these bacteria, highlighting their importance in various environments.

![Copyright © 2009 Pearson Education Inc., publishing as Pearson Benjamin Cummings
5. Methanotrophs and Methylotrophs
Methanotrophs
Use CH4and a few other one-carbon (C1) compounds
as electron donors and source of carbon
Widespread in soil and water
Obligate aerobes
Morphologically diverse
Methylotrophs
Organisms that can grow using carbon compounds
that lack C-C bonds [(CH3)2N (trimethylamine)HCOO-
(formate), CH3OCOO CH3 (Dimethyl carbonate),
(CH3)2SO (dimethyl sulfoxide), CH3OH (methanol),
CH3NH2 (methylamine), CH3)2NH (dimethylamine)]
Most are also methanotrophs – use CH4](https://image.slidesharecdn.com/editedproteobacteriapowerpoint-copy-240617062138-e44ccdc5/85/Edited_Proteobacteria_powerpoint-Copy-ppt-85-320.jpg)








































![Copyright © 2009 Pearson Education Inc., publishing as Pearson Benjamin Cummings
Bacterial Bioluminescence
Light emission
Most are marine isolates (Vibrio, Alivibrio, Photobacterium)
but some terrestrial
May colonise specialized light organs of some maring fish
& squids or on dead skin of crustacean / fish
V. cholera & V. vulnificus are pathogens; care when
handling luminous bacteria
Bioluminescence only when oxygen is present
LuxCDABE gene products, luciferase, oxygen and a
population density response (acyl homoserine [AHL],
quorum sensing) is required](https://image.slidesharecdn.com/editedproteobacteriapowerpoint-copy-240617062138-e44ccdc5/85/Edited_Proteobacteria_powerpoint-Copy-ppt-126-320.jpg)







































